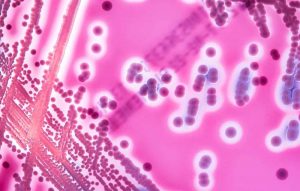
necrotizing-fasciitis-flesh-eating-disease

Flesh-eating bacteria could cause severe infections that cause amputation or death. Although this case is […]
Flesh-eating bacteria could cause severe infections that cause amputation or death. Although this case is […]
Related News
Headlines
Tag: Necrotizing fasciitis
No More Posts Available.
No more pages to load.